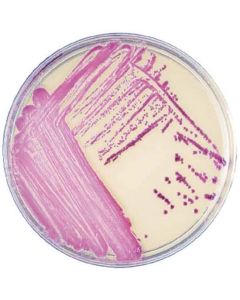
BD Bbl™ Chromagar™ Mrsa Ii Plate, 100mm, 20/PK (Short Dated) (Drop

We use cookies to make your experience better. To comply with the new e-Privacy directive, we need to ask for your consent to set the cookies. Learn more.
Plated Media
-

Quality Bio LB Agar Plates with 100ug/ml Ampicillin Slv/10 (more info)
List Price $40.85 Your Price $40.85NETA PART: QB-340-108-231 MFG. PART: 340-108-231 -

Quality Bio LB Agar Plates with 50ug/ml Ampicillin Slv/10 (more info)
List Price $41.22 Your Price $41.22NETA PART: QB-340-107-231 MFG. PART: 340-107-231 -

Quality Bio Bacterial Growth Media, 10 x 25 mL (more info)
List Price $42.83 Your Price $42.83NETA PART: QB-340-147-231 MFG. PART: 340-147-231 -

Quality Bio LB Agar Plates with 70ug/ml Kanamycin Slv/10 (more info)
List Price $48.02 Your Price $48.02NETA PART: QB-340-170-231 MFG. PART: 340-170-231 -

Quality Bio LB (Luria Bertani) Agar Plates Slv/10 (more info)
List Price $55.63 Your Price $55.63NETA PART: QB-340-025-231 MFG. PART: 340-025-231 -

BD Plated Media, Prepared, Standard Methods Agar, Mono-Plate Format, 20/PK (more info)
List Price $102.84 Your Price $102.84NETA PART: BD-297030 MFG. PART: 297030 -

BD BBL™ CHROMagar™ Staph Aureus Plate 20/PK (more info)
List Price $180.13 Your Price $180.13NETA PART: BD-214982 MFG. PART: 214982 -

BD Bottle Plate Count Agar, 500G (more info)
List Price $222.58 Your Price $222.58NETA PART: BD-247940 MFG. PART: 247940 -

BD Plated Media, Prepared, Columbia CNA with 5% Sheep Blood and MacConkey II Agar Bi-Plate Format, 100/PK (more info)
List Price $247.67 Your Price $247.67NETA PART: BD-221601 MFG. PART: 221601 -
BD Bbl™ Chromagar™ Mrsa Ii Plate, 100mm, 20/PK (Short Dated) (Drop (more info)
List Price $292.01 Your Price $292.01NETA PART: BD-215228 MFG. PART: 215228
